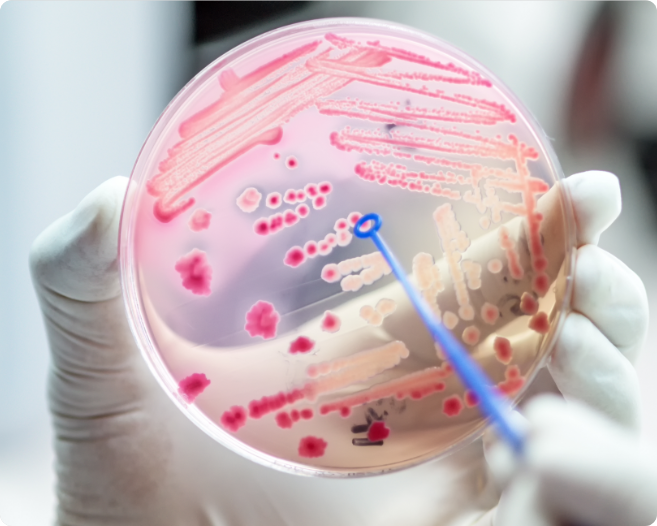

The Infectious Diseases Society of America has three key priorities for strengthening the field of infectious diseases and protecting public health.
These include building a strong and dynamic ID workforce to address increasing health care challenges, tackling the growing threat of antimicrobial resistance and providing national leadership in developing evidence-based clinical guidelines. IDSA advocates for policies and investments that support ID professionals, promote the responsible use of antimicrobials and ensure health care providers have access to expert guidance for diagnosing and treating infectious diseases.

On June 15, 2023, in Washington, D.C., Axios health care editor Tina Reed hosted conversations examining ways to bolster the health workforce and improve pandemic preparedness. Guests included HRSA administrator Carole Johnson, Howard University Hospital vice president and chief nursing officer Dr. India Medley and Sen. Tina Smith (D-Minn.). A View From the Top sponsored segment featured IDSA Treasurer Dr. Jeanne Marrazzo.
ID professionals are needed now more than ever to tackle the many medical mysteries of our rapidly changing world. That is why a robust pipeline and pathway for ID professionals is so important. Ensuring we have enough ID experts to meet the challenges of the future is only possible if ID experts are compensated in accordance with their value to hospitals and health systems; payers; other medical professionals; and patients. In recognition of ID experts’ critical contributions to public health, Congress is currently considering legislation, like the Biopreparedness Workforce Act and the PREVENT Act, to support necessary investments in the profession.
Antibiotics, antivirals and other antimicrobials have saved millions of lives worldwide, but these drugs are losing their effectiveness, a circumstance commonly known as antimicrobial resistance. The growing problem of resistance has undermined the usefulness of some antimicrobials, resulting in more than 23,000 deaths each year and placing public health and national security at serious risk. Furthermore, treating antibiotic-resistant infections costs the U.S. health care system an estimated $21-34 billion annually. ID experts are working to counter these “bad bugs” and save lives.

Clinical guidelines are statements developed to inform medical professionals’ and patients’ decisions about appropriate health care for specific clinical circumstances. Guidelines are maintained by both governmental groups (for example, the National Institutes of Health) and nongovernmental organizations (for example, the Infectious Diseases Society of America) to ensure best practices in diagnosis and treatment. IDSA published guidance on diagnosis, treatment and infection prevention practices related to the COVID-19 pandemic. Clinical guidelines are a critical component to helping practitioners respond effectively and quickly to outbreaks, epidemics and pandemics.